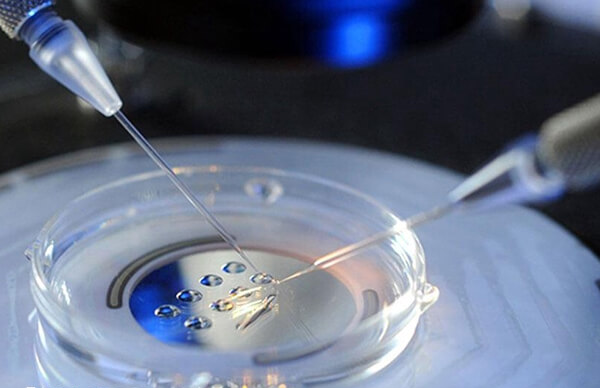
俄罗斯NGC有独立胚胎实验室

去俄罗斯做试管婴儿,选择icrm医院还是ngc医院好?
发布:2025-11-05 19:00:17
浏览136次
问题描述:
俄罗斯icrm生殖中心的试管水平更高。ICRM医院单周期试管婴儿成功率最高可达到75%以上,平均在70%-75%,属于上等水平,可比肩一些水平比较高的美国。而ngc生殖中心单周期试管婴儿成功率在65%-75%。根据平均水平来看俄罗斯icrm生殖中心比ngc生殖中心的试管水平更高一些。但是在我看来一家医院做试管的技术水平高低是由多方面因素决定的,还是要选择更适合自己情况的医院做试管婴儿最合适。
最佳答案
俄罗斯icrm生殖中心的试管水平更高。ICRM医院单周期试管婴儿成功率最高可达到75%以上,平均在70%-75%,属于上等水平,可比肩一些水平比较高的美国。而ngc生殖中心单周期试管婴儿成功率在65%-75%。根据平均水平来看俄罗斯icrm生殖中心比ngc生殖中心的试管水平更高一些。但是在我看来一家医院做试管的技术水平高低是由多方面因素决定的,还是要选择更适合自己情况的医院做试管婴儿最合适。
俄罗斯icrm医院还是ngc医院做试管婴儿好
俄罗斯ngc国际生殖中心和俄罗斯icrm国际生殖医学中心是位于俄罗斯圣彼得堡的两家著名的体外受精医院。下面就来分别介绍一下这两家医院的优势。
一、俄罗斯ICRM国际生殖医学中心的优势
- 1. 成功率高:俄罗斯8家体外受精医院中,ICRM医院成功率较高,高于美国部分体外受精医院;
- 2. 体外受精技术发展:ICRM医院是综合性生殖医学中心。医院支持第一代、第二代和第三代体外受精和其他辅助生殖技术,以及完善的医疗设施和设备;
- 3. 成本适中:ICRM国际生殖医学中心体外受精的成本不高也不低,从俄罗斯试管受精的价格来看,超过10万只可视为正常范围。
二、俄罗斯NGC国际生殖中心优势
- 1. 独立实验室:俄罗斯NGC医院拥有自己独立的世界先进的胚胎实验室,还有储备丰富的卵子库和精子库;
- 2. 成功率高:NGC体外受精医院成功率高达75%,但成功率范围波动很大,低时只有65%;
- 3. 先进的体外受精技术:NGC医院支持产前诊断、体外受精、PGD、PGS等辅助生殖技术。
NGC医院成立时间相对来说比较短,而ICRM医院成立时间久,但是ICRM医院的生殖类的科室在整个医院占比不高。如果是单单按生殖医生数量、设备、规模、研发投入来看,ICRM生殖科反而比不上生殖专科医院NGC。
好孕交流群 分享心理 链接关系 共同目标
最新问题
- 青岛妇幼保健院人工授精哪个医生好?附4大生殖专家推荐 2026-06-25
- 郑州大学第二附属医院做试管婴儿准备5万够吗? 2026-06-25
- 山东省妇幼保健院试管婴儿成功率怎么样?能达到50%吗? 2026-06-24
- 济宁医学院附属医院生殖科医生哪位好?做试管婴儿找谁? 2026-06-24
- 滨州试管婴儿费用大约多少?准备3万元够吗? 2026-06-23
- 郑州三代试管婴儿医院哪个好?郑大三附院怎么样? 2026-06-23
热点问题榜
网友关注的问题
排名
主题
阅读量
-
13828 -
212754
-
312573
-
411571
-
511522
-
611331
-
711148
-
811003
-
910917
-
1010328
热门资讯
助您好孕多多
医院




